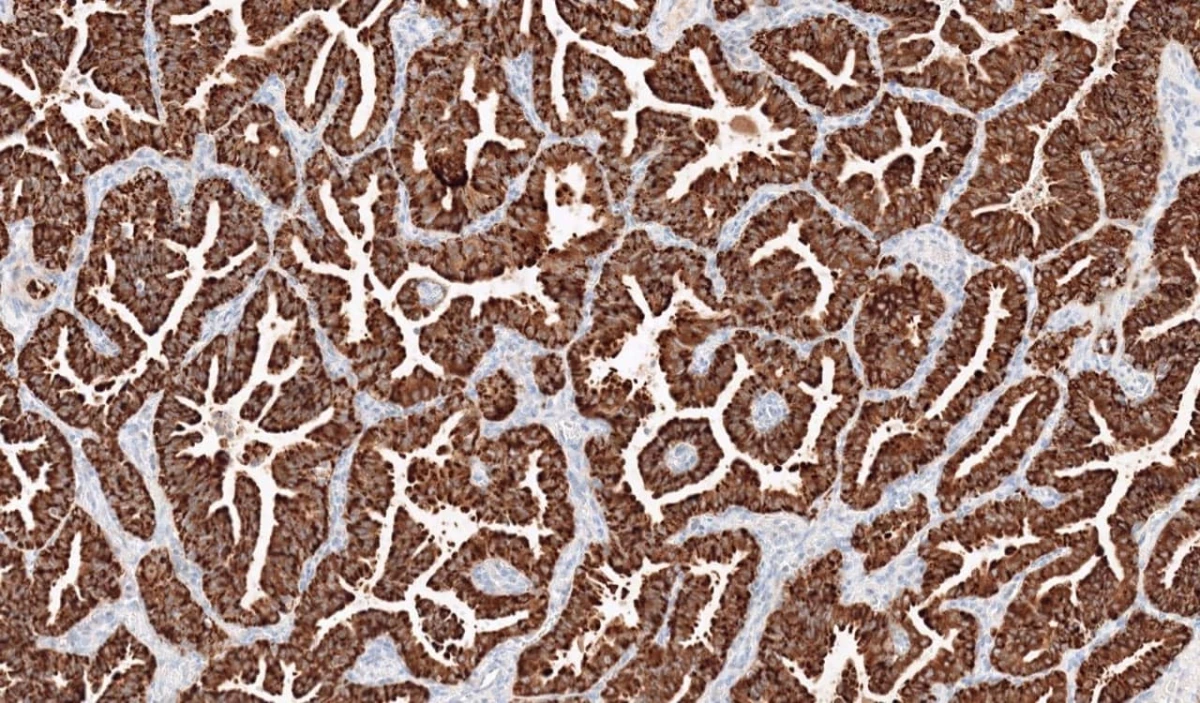
Immunohistochemistry: ROS1

تفاصيل التحليل
تحليل الكيمياء النسيجية المناعية لبروتين (ROS1)
كشف الخلل الجيني في خلايا سرطان الرئة لتحديد القابلية للعلاجات الموجهة والذكية، مما يفتح آفاقاً جديدة لعلاج أكثر فعالية وأقل آثاراً جانبية.
الصورة التوضيحية المرتبطة بهذا التحليل